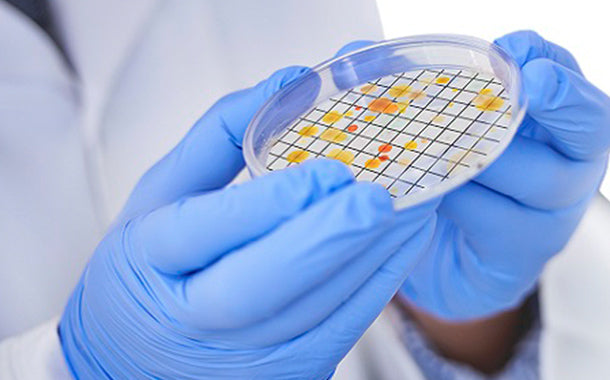
微生物検査

ライフサイエンス
ニュース & トピック

2026.06.05 SAFETY GVSジャパン セーフティ部門は、米子どてらい市/鹿児島どてらい市に出展します。 米子どてらい市: 6/12(金)~13(土): 米子産業体育館鹿児島どてらい市: 6/25(木)~27(土):西原商会アリーナ どてらい市限定の大変お得な特典もご用意しております! 是非お越しください。 ★ご来場には各どてらい市公式ホームページからの事前登録が必要です。
もっと見る

2026.05.11 LIFE SCIENCES GVSライフサイエンス部門は、5月20日(水)~22日(金)3日間 幕張メッセにて行われる再生医療EXPO東京2026に本年も出展します。 大学、製薬・化粧品メーカー、再生医療・細胞医療実施企業の研究者等の方々に向け、細胞培養製品(セルファクトリー、ローラーボトル、滅菌三角フラスコ、細胞培養フラスコ、ディッシュ、プレート)などを出展予定です。...
もっと見る